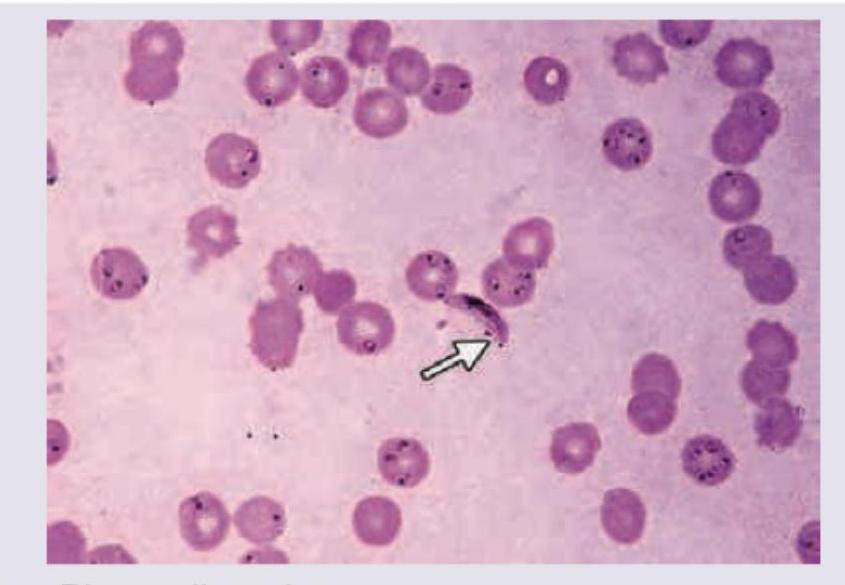
Image for question 173

A patient with following peripheral smear and X-ray spine will present with:

A 6-year-old Afro-American boy presents with acute abdomen and nonhealing ulcer on medial malleolus. Peripheral smear is shown. The most likely cause of this condition is:

A 34-year-old lady presents with high-grade fever with chills and rigors. On examination, a firm spleen is felt 3 cm below costal margin. Peripheral smear was prepared. Diagnosis is:
All are true about the condition shown except:

Which of the following is the most common cause of death in this condition?

If the mean QRS vector in lead I is positive and in lead III is negative, what is the axis deviation?

The ECG shows a heart rate of 40 bpm, left axis deviation, and QRS duration >120 msec. There are deep monophasic S waves in V1-V3, broad monophasic R waves in lateral leads I, aVL, V5-V6, and absent Q waves in lateral leads with M shaped notch in peak of R wave in V5-V6. What is the diagnosis?

A patient presented with TCA toxicity. The ECG shows broad complex QRS with duration of 160 msec and ST segment elevation in V1 and V2. What is the most appropriate management?

A 30-year-old lady with scleroderma presents with progressive dyspnea on exertion. Which of the following is incorrect about the ECG finding?

What is the axis in the ECG provided?

Explanation: ***Hand-foot syndrome*** - The peripheral smear shows numerous **sickle cells** (elongated, crescent-shaped red blood cells), indicating **sickle cell anemia**. The X-ray depicts **H-shaped vertebrae** or "fish-mouth vertebrae", which is a characteristic finding in sickle cell disease due to chronic bone infarcts. - **Hand-foot syndrome (dactylitis)** is an initial presentation of sickle cell anemia in infants and young children, characterized by painful swelling of the hands and feet caused by **vaso-occlusion** in the small bones. *Black urine* - **Black urine (alkaptonuria)** is associated with an inborn error of metabolism where homogentisic acid accumulates, leading to ochronosis, not sickle cell disease. - This symptom is not typical for the peripheral smear and X-ray findings presented. *Elevated haptoglobin* - Haptoglobin binds to **free hemoglobin** and is *decreased* in hemolytic anemias like sickle cell disease, as accelerated red blood cell destruction leads to its consumption. - Therefore, an elevated haptoglobin level would argue against **hemolytic anemia**. *Splenomegaly with gallstones* - While chronic hemolysis in sickle cell disease can lead to **gallstones** (pigment gallstones), most patients with sickle cell anemia develop **autosplenectomy** (functional asplenia) by childhood or early adulthood due to repeated splenic infarcts, rather than persistent splenomegaly. - Splenomegaly can occur in early childhood but typically regresses as the spleen undergoes fibrosis.
Explanation: ***Substitution of single amino acid base*** - The image shows numerous **sickle cells** (elongated, crescent-shaped red blood cells), which are characteristic of **sickle cell anemia**. - Sickle cell anemia is caused by a **point mutation** (a single amino acid substitution) in the beta-globin gene, where valine replaces glutamic acid at the sixth position. *Trinucleotide repeat* - **Trinucleotide repeat disorders** (e.g., Huntington's disease, Fragile X syndrome) involve an abnormal expansion of three-nucleotide sequences. - They present with neurological or developmental symptoms, not the hematological features of sickle cell disease. *Antibody to RBC membrane* - **Antibodies to RBC membrane** cause conditions like **autoimmune hemolytic anemia**, where red blood cells are destroyed by the immune system. - While it can cause anemia, the characteristic **sickle shape** of the red blood cells, as seen in the smear, is not a feature of autoimmune hemolytic anemia. *Genomic imprinting* - **Genomic imprinting** is an epigenetic phenomenon where certain genes are expressed in a parent-of-origin-specific manner (e.g., Prader-Willi syndrome). - This mechanism is not involved in the pathogenesis of sickle cell disease.
Explanation: ***Plasmodium vivax*** - The image distinctly shows **amoeboid trophozoites**, **enlarged red blood cells** with **Schüffner's dots**, and various stages of parasites within the red blood cells, which are characteristic of *P. vivax* infection. Additionally, a **banana-shaped gametocyte** is visible (indicated by the arrow), which can be seen in *P. vivax* but is more typically associated with *P. falciparum* (though it's not the primary distinguishing feature here). - Clinical features like **high-grade fever with chills and rigors** and a **firmly palpable spleen** are consistent with malaria, and the microscopic findings on the peripheral smear confirm *P. vivax*. *Plasmodium falciparum* - While *P. falciparum* causes severe malaria with similar systemic symptoms and can feature **banana-shaped gametocytes**, it typically does not cause **enlargement of red blood cells** or prominent **Schüffner's dots**. - Its trophozoites are often **ring forms**, and multiple parasites can infect a single red blood cell; the morphology in the image is more consistent with *P. vivax*. *Amebic liver abscess* - This condition is caused by *Entamoeba histolytica* and primarily presents with **fever** and **right upper quadrant pain**, sometimes referred to the shoulder. - Diagnosis is usually made by imaging (e.g., ultrasound, CT scan) and serology; it does not involve parasites in red blood cells on a peripheral smear. *Infectious mononucleosis* - Caused by the **Epstein-Barr virus**, it presents with fever, fatigue, **lymphadenopathy**, and **splenomegaly**, but not with parasitic forms in red blood cells. - The characteristic finding on a peripheral smear would be **atypical lymphocytes** (Downey cells), not malarial parasites.
Explanation: ***Bilateral hilar lymphadenopathy with caseating granulomas*** - Sarcoidosis, depicted in the images (bilateral hilar lymphadenopathy on chest X-ray and **non-caseating granulomas** on histology), is characterized by **non-caseating** (not caseating) granulomas. - **Caseating granulomas** are typical of tuberculosis and certain fungal infections, not sarcoidosis. *Kveim-Siltzbach procedure is an intradermal test* - The Kveim-Siltzbach test is an **intradermal injection** of sarcoidosis tissue extract, which would reliably induce a granulomatous reaction in patients with active sarcoidosis. - While historically used, it is now rarely performed due to unavailability of standardized antigen and the risk of disease transmission. *Increased CD4/CD8 Ratio >3.5 in Bronchoalveolar Lavage* - An elevated **CD4/CD8 ratio**, typically greater than 3.5, in **bronchoalveolar lavage (BAL)** fluid is a characteristic finding in active pulmonary sarcoidosis. - This indicates an accumulation of helper T cells in the lungs, contributing to granuloma formation. *Lofgren syndrome leads to uveitis* - **Löfgren syndrome** is an acute form of sarcoidosis characterized by the triad of **hilar lymphadenopathy**, **erythema nodosum**, and **arthralgia**. - While it is a specific presentation of sarcoidosis, **uveitis** is also a known manifestation of sarcoidosis but is not a defining characteristic of Löfgren syndrome itself; however, sarcoidosis can cause uveitis.
Explanation: ***Cardiac failure*** - The image reveals **myocarditis** with **inflammatory infiltrates** and **myocyte necrosis**, indicative of direct myocardial injury. - Severe myocarditis can lead to significant impairment of cardiac function, resulting in **dilated cardiomyopathy** and ultimately **heart failure**, which is the most common cause of death. *Bacterial endocarditis* - This condition involves **vegetations on heart valves**, often leading to **valvular insufficiency** or **embolism**, but it is not primarily a disease of the myocardium itself causing widespread failure as depicted. - The image does not show evidence of valvular vegetations or bacterial colonies typical of endocarditis. *Ball thrombus in left atria* - A ball thrombus typically forms in the **left atrium** due to conditions like **mitral stenosis** or atrial fibrillation, potentially causing **embolic events** or sudden obstruction. - This is a sequela of other cardiac diseases and not a primary myocardial pathology leading to widespread inflammation and necrosis as seen. *Acute coronary insufficiency* - Acute coronary insufficiency is characterized by **ischemia** due to reduced blood flow through the **coronary arteries**, usually caused by **atherosclerotic plaque rupture** and thrombosis. - The histological features of myocarditis, with diffuse inflammatory cells and scattered myocyte damage in the image, are distinct from the typical pattern of **ischemic necrosis** found in myocardial infarction.
Explanation: ***Left axis deviation*** - A **positive QRS vector in lead I** means the overall electrical activity is moving towards the positive pole of lead I (i.e., towards the patient's left). - A **negative QRS vector in lead III** means the overall electrical activity is moving away from the positive pole of lead III. When combined, these findings indicate the axis is shifted to the left, typically between -30° and -90°. *Normal axis* - A normal axis would typically show **positive QRS vectors in both lead I and lead III**. - The electrical forces are directed generally downwards and to the left, usually between -30° and +90°. *Right axis deviation* - Right axis deviation is characterized by a **negative QRS vector in lead I** and a positive QRS vector in lead aVF or lead III. - This signifies the electrical axis is shifted to the right, usually between +90° and +180°. *Extreme axis deviation* - Extreme axis deviation (also known as "indeterminate" or "northwest" axis) is indicated by **negative QRS vectors in both lead I and lead aVF**. - This represents an axis between -90° and -180°, an unusual and often pathological finding.
Explanation: ***LBBB*** - The ECG criteria for **LBBB** include a **QRS duration >120 msec** (broad QRS), a **broad, monophasic R wave** or "M-shaped" R wave (sometimes called rabbit ears) in **lateral leads (I, aVL, V5-V6)** signifying delayed activation of the left ventricle, and **deep S waves in V1-V3**. - The presence of **left axis deviation** can also be associated with LBBB, although not a primary diagnostic criterion. The absence of Q waves in lateral leads further supports delayed septal activation. *RBBB* - **RBBB** is characterized by a widened QRS complex (>120 msec) with an **RSR' pattern (M-shaped)** in leads **V1 and V2**, representing delayed right ventricular activation. - It typically presents with a **wide, slurred S wave in lateral leads (I, aVL, V5-V6)**, which is opposite to the findings described in the question. *Left anterior fascicular block* - **Left anterior fascicular block (LAFB)** is characterized by **left axis deviation (usually -45 to -90 degrees)** and a **normal QRS duration** (<120 msec), along with an absent Q wave and tall r wave in aVL, and a qR pattern in lead I. - It does not involve significant QRS widening or the specific morphology (broad R waves in lateral leads, deep S waves in V1-V3) seen in this ECG. *Left posterior fascicular block* - **Left posterior fascicular block (LPFB)** is rare and is characterized by **right axis deviation** and a **normal QRS duration** (<120 msec). - It does not present with the specific wide QRS and characteristic QRS morphology in precordial and lateral leads observed in this ECG tracing.
Explanation: ***Broad complex QRS: Soda bicarbonate*** - The ECG shows a **broad QRS complex** (160 msec), which is a characteristic finding in TCA toxicity due to the drug's **sodium channel blocking effects**. - **Sodium bicarbonate** is the treatment of choice for TCA toxicity with QRS widening, as it **increases extracellular sodium concentration** and **alkalinizes the blood**, thereby overcoming the sodium channel blockade. *Narrow complex QRS: Lidocaine* - This patient presents with a **broad complex QRS**, making lidocaine an inappropriate first-line treatment for this specific ECG finding in TCA toxicity. - Lidocaine is generally contraindicated in TCA toxicity because it can exacerbate the **sodium channel blockade** and arrhythmogenic effects. *ST segment elevation: Aspirin* - While ST segment elevation can be seen in TCA toxicity (due to direct myocardial effects or coronary vasospasm), the primary and most life-threatening ECG finding requiring immediate intervention is the **broad QRS complex**. - Aspirin is a **platelet aggregation inhibitor** and would not address the underlying cardiotoxicity of TCAs, nor would it correct the wide QRS or arrhythmias. *T wave inversion: Beta-blockers* - T-wave inversion can occur in various cardiac conditions, including TCA toxicity, but it is not the most critical or specific finding warranting immediate intervention in this context. - **Beta-blockers** are generally **contraindicated** in TCA toxicity because they can worsen **hypotension** and heart block already caused by the overdose.
Explanation: ***Heart rate of 75 bpm*** - This ECG shows a heart rate of approximately 100 bpm (one large box is 0.2 seconds; 300/3 = 100). Therefore, a heart rate of 75 bpm is **incorrect**. - The rhythm is generally regular, and the calculation of heart rate involves counting the number of R waves in a 6-second strip and multiplying by 10, or by dividing 300 by the number of large squares between R waves. *Right axis deviation* - The QRS complex in lead I is predominantly negative, and in aVF it is predominantly positive, which indicates **right axis deviation**. - Right axis deviation suggests possible **right ventricular hypertrophy** or strain, consistent with pulmonary hypertension which can occur in scleroderma. *T wave inversion in V1-V3* - The ECG clearly shows **T-wave inversions** in leads V1, V2, and V3. - This pattern can be suggestive of **right ventricular strain** or hypertrophy, commonly seen in pulmonary hypertension. *rSR' pattern in V1* - In lead V1, there is a small initial r wave, followed by an S wave, and then a larger R' wave, forming an **rSR' pattern**. - This morphology is characteristic of an **incomplete right bundle branch block (IRBBB)**, which is often associated with right ventricular volume or pressure overload, such as in pulmonary hypertension.
Explanation: ***Left axis deviation*** - The **QRS complex** is predominantly **positive in Lead I** and predominantly **negative in Lead aVF**. - This combination indicates that the mean QRS electrical vector lies between **-30° and -90°**, which is characteristic of left axis deviation. *Normal* - A **normal axis** typically shows a predominantly **positive QRS complex** in both Lead I and Lead aVF. - This ECG shows a negative QRS in aVF, ruling out a normal axis. *Right axis deviation* - **Right axis deviation** is characterized by a predominantly **negative QRS complex** in Lead I and a predominantly **positive QRS complex** in Lead aVF. - This ECG shows the opposite pattern in Lead I (positive), ruling out right axis deviation. *Extreme axis deviation* - **Extreme axis deviation**, sometimes called "northwest axis," is present when the **QRS complex** is predominantly **negative in both Lead I and Lead aVF**. - In this ECG, Lead I is positive, so extreme axis deviation is not present.
Get full access to all questions, explanations, and performance tracking.
Start For Free